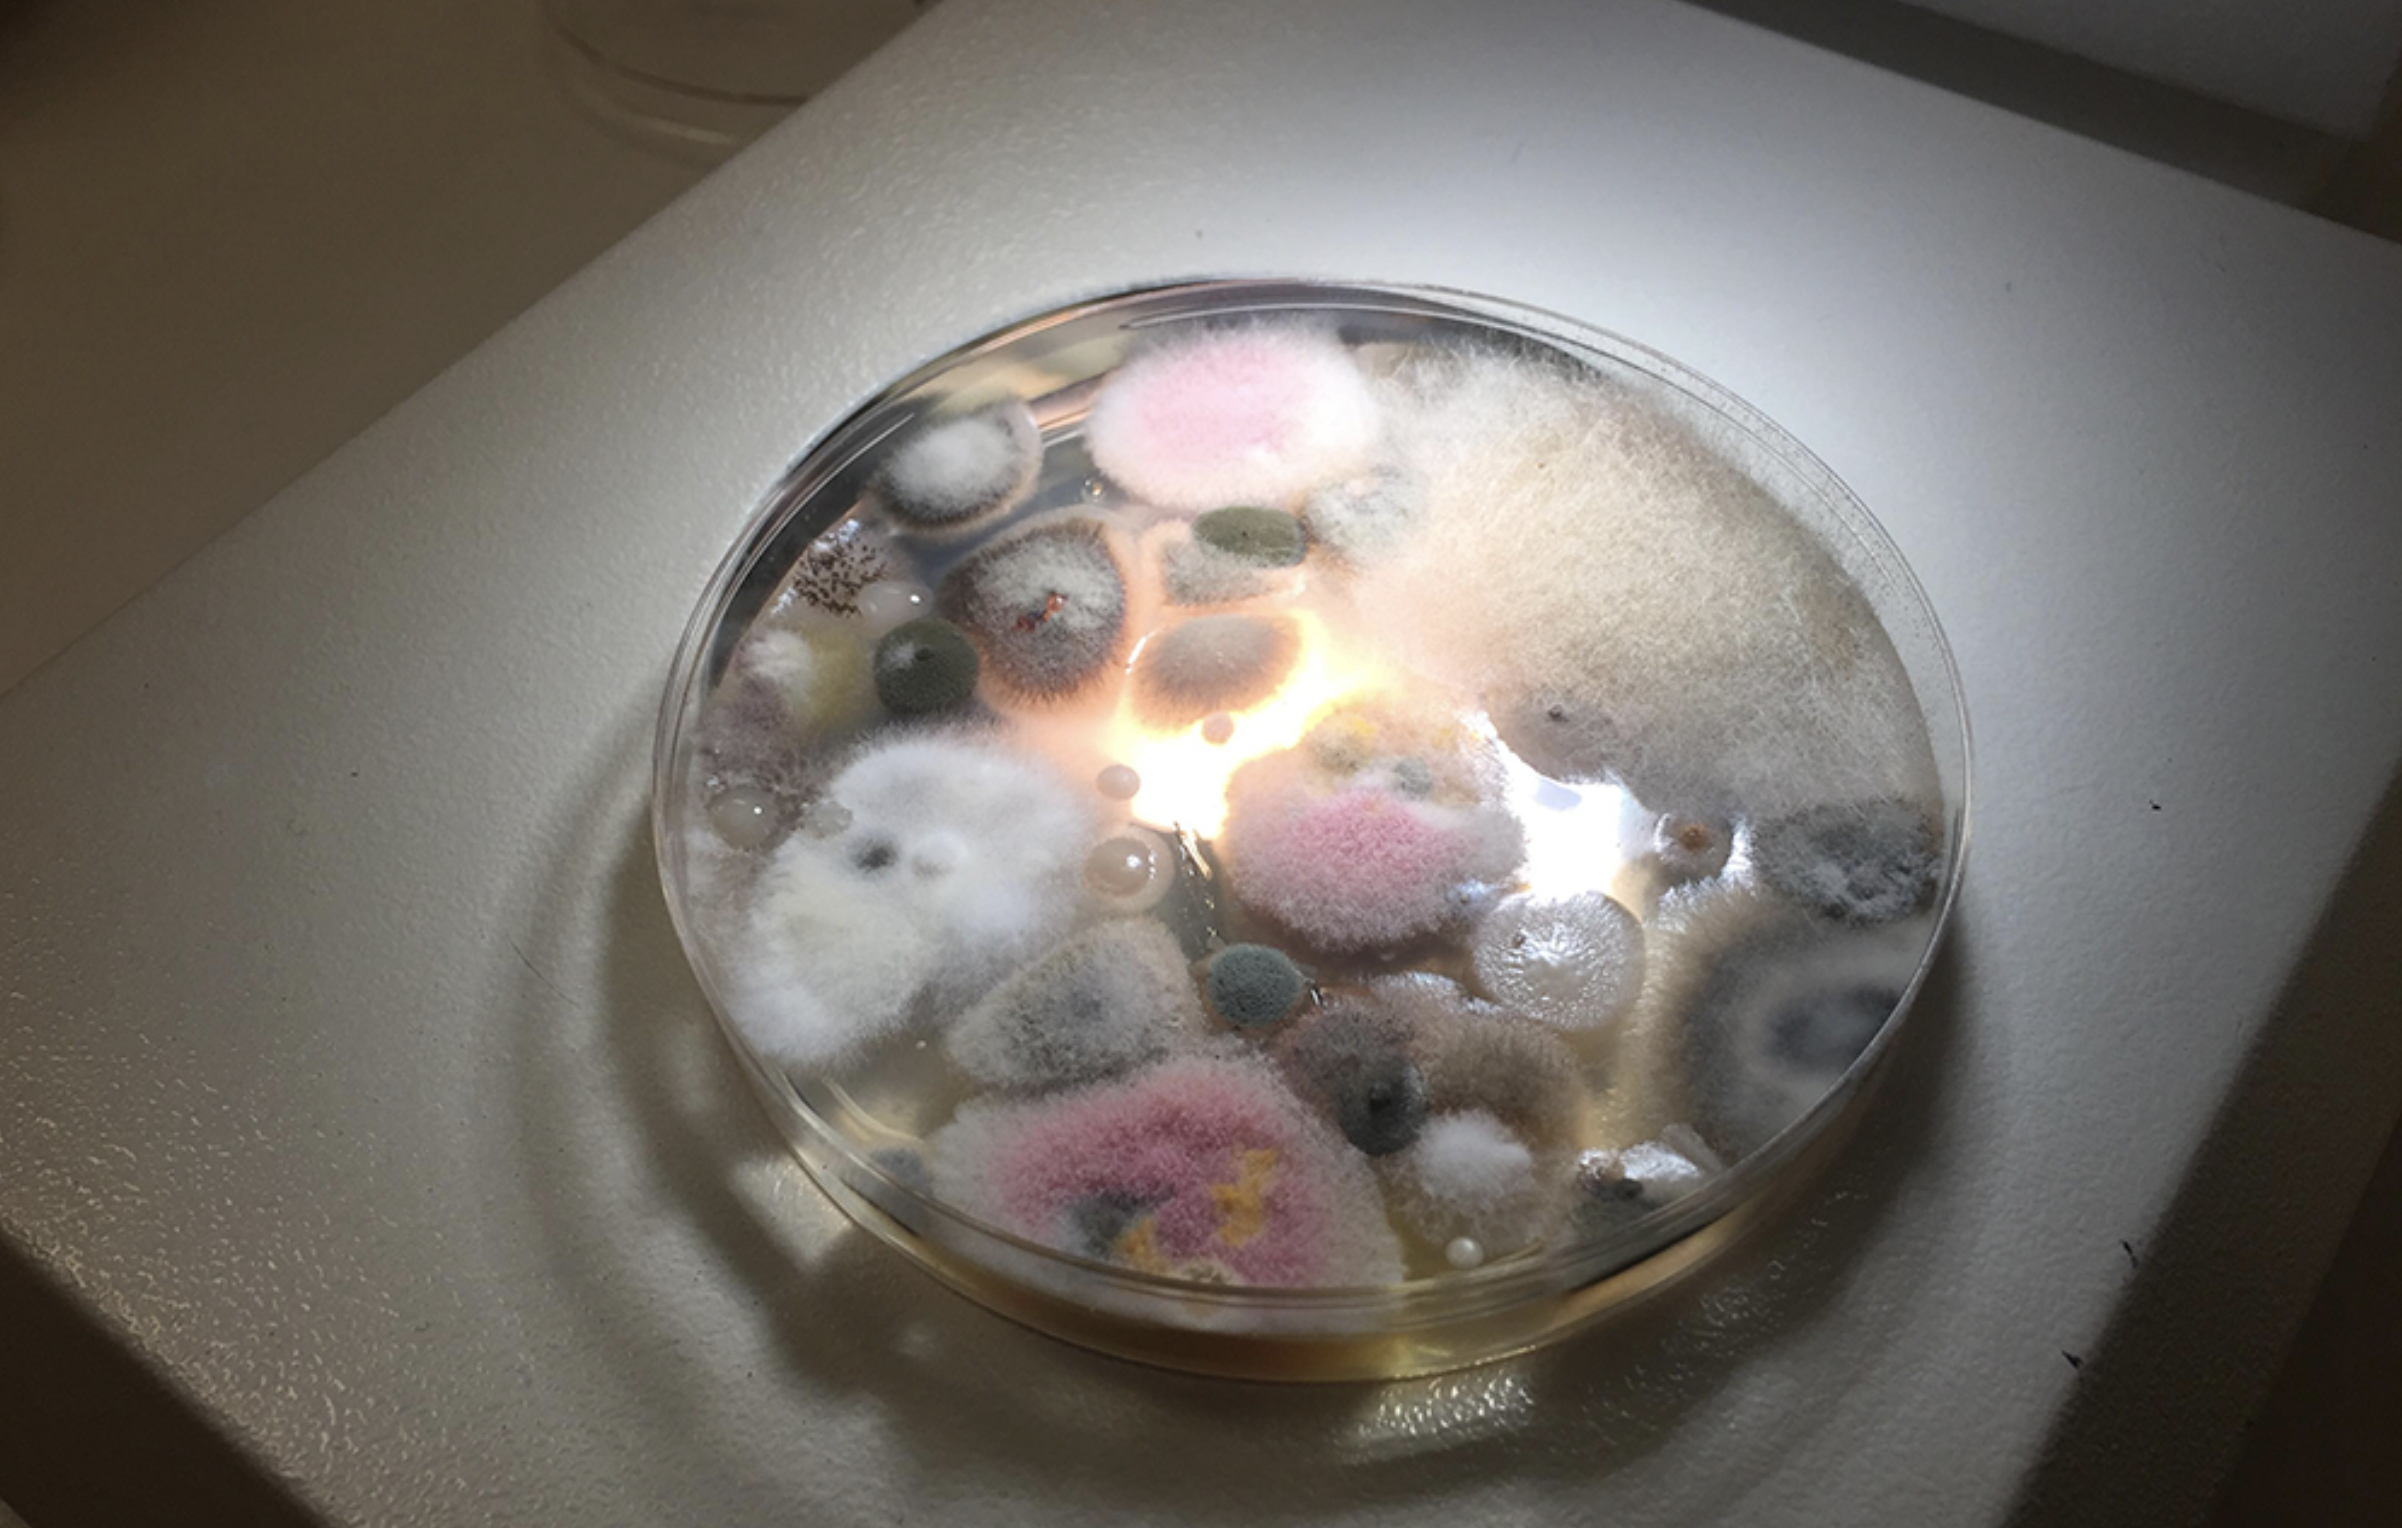

Fungink is an ongoing experiment around exploring color possibilities with fungi.
In the earliest experiments I obtained different samples of environmental fungi to see color and texture possibilities.
GingkoCreativeResidency_DianaSanchez
Lyophilisation of the samples to obtain dry material and then trying to pulverize it with a mortar. Mixing it with water to use it as an ink for a watercolor brush